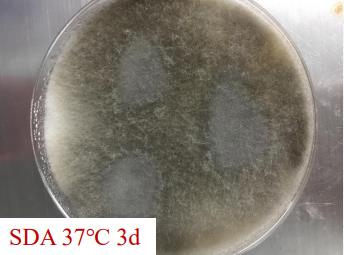
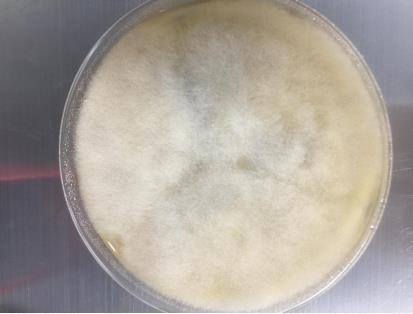

【第一百三十三期】基层检验网形态学培训
【第一百三十三期】基层检验网形态学培训
每周一次,每次几张,只要您坚持来,抽出几分钟的时间,相信您的识图能力会不知不觉的提升哦
1、请指出下方的真菌名称:

答案:青霉
解析:菌落特点:SDA 琼脂上呈灰蓝色短绒状菌落,有放射状沟纹,菌落中心颜色较浅,外周颜色稍深,呈同心圆分布。
镜下特点:帚状枝两轮生或单轮生,瓶梗较短粗;分生孢子圆形或者椭圆形,光滑,呈长链状排列。
形态学难以区分青霉属内菌种,对有临床意义的菌株可以进一步通过 MALDI-TOF 质谱或者基因测序加以鉴别。
2、请指出下方的真菌名称:

答案:篮状菌
菌落特点:在 SDA 琼脂上,菌落正面粉末状或绒毛状、微隆起,白色边缘中央呈淡蓝灰绿色,背面放射状皱纹。
镜下特点:篮状菌气生菌丝聚积成绳索状,菌丝有横隔,产孢结构扫帚状向外散射;分生孢子梗直立,光滑或粗糙,对称双轮生或偶尔单轮生。分生孢子细胞呈瓶状,大约与分生孢子的长度相等,尖瓶状,稀有。分生孢子单细胞,通常椭圆形至纺锤形,球形少见。
临床意义:很少引起人类感染,即便从患者标本中重复分离到也不表明其为致病菌。如无菌部位阳性,应及时与临床沟通。
以上两种丝状真菌是呼吸道标本中常见的污染菌,无菌部位标本中检出应及时沟通临床。
3、请指出下方的真菌名称:

答案:根霉属
解析:菌落特点:SDA 琼脂上,菌落质地絮状,初期白色稀疏绒毛状,后呈暗灰褐色,且扩散性生长充满平板。
镜下特点:宽大且不规则、无隔菌丝,分枝呈直角。孢囊梗直立或弯曲,呈褐色,通常以 1~4 个为一组或丛生,常成对,孢子囊呈灰黑色,球形,囊轴近球形或长形,孢子囊孢子近球形,具有梭角及线状条纹,假根指状不分枝。
鉴别:可通过根霉属孢囊梗与假根对生的特点与毛霉属鉴别;根霉属假根与孢囊梗相对、孢子囊球形的特点与横梗霉属及小克银汉霉属鉴别。
临床意义:当机体免疫功能低下时,易侵犯血管内皮,且进展迅速,轻者导致小血管的血栓形成,从而出现局部组织的肿胀和坏死,重者可致播散性感染,产生皮肤、鼻、脑、消化道及呼吸道等处病变,病死率高。
4、请指出下方的真菌名称:

答案:毛霉目
解析:菌落特点:SDA 琼脂上,菌落质地絮状,气生菌丝生长茂盛,呈白色至暗黄褐色,菌落背面浅黄色。
镜下特点:球形孢子囊淡褐色,孢囊梗单个或者分枝,无囊托、假根。
临床意义:毛霉病与血管侵犯相关,可引起患者的肺部感染、鼻眶脑感染、皮肤及皮下感染、播散性感染等。

5、请指出下方的真菌名称:



答案:烟曲霉(白化株)
菌落形态:典型的菌落为蓝绿色;不育变种为白色绒毛状,生长速度较常规烟曲霉慢,菌落平整,或表面可见皱褶或放射状条纹,因产孢活动减弱致使菌落中央烟绿色产孢区不明显。菌落背面白色至淡黄色。
镜下形态:虽菌落为白色,但镜下形态典型,可有产孢减弱的表现,分生孢子头减少,分生孢子圆形,数量也少。
可通过 MALDI-TOF 质谱或者基因测序进行验证。
临床意义:有文献标明产孢异常烟曲霉菌株的毒力弱于常规烟曲霉,但国内外均有烟曲霉白化株致患者罹患曲霉病的报道。
参考书籍:《临床真菌学图谱 第三部》主编:徐英春,执行主编:谢秀丽,张丽,陈东科
参考文献:
[1]SALMANTON-GARCIA J,SPRUTE R,FungiScope European Confederation of Medical Mycology/The Interational Society
for Human and Animal Mycology Working Group,et al. COVID-19-associated pulmonary aspergillosis[J]. Emerg Infect
Dis,2021,27(4):1077-1086.
[2]PASERO D, SANNA S, LIPERI C, et al. A challenging complication following SARS-CoV-2 infection: a case of pulmonary
mucormycosis [J]. Infection, 2021, 49(5):1055-1060.
[3]ALANIO A, DELLIÈRE S, FODIL S, et al. Prevalence of putative invasive pulmonary aspergillosis in critically ill patients with
COVID-19 [J]. Lancet Respir Med,2020,8(6): e48-e49.
[4]VAN ARKEL ALE, RIJPS'TRA TA, BELDERBOS HNA.et al. COVID-19-associated pulmonary aspergillosis [J].Am J Respir Crit
Care Med,2020,202(1): 132-135.
[5]WANG J, YANG Q, ZHANG PP, et al. Clinical characteristics of invasive pulmonary aspergillosis in patients with COVID-19
in Zhejiang, China: a retrospective case series[J].Crit Care, 2020,24(1):299.
感谢:重医大附一院检验科和重医附属大学城医院提供的内容。


